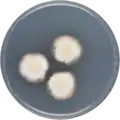
Aspergillus desertorum growing on CYA plate

Aspergillus desertorum
| Aspergillus desertorum | |
|---|---|
| Scientific classification | |
| Kingdom: | Fungi |
| Division: | Ascomycota |
| Class: | Eurotiomycetes |
| Order: | Eurotiales |
| Family: | Aspergillaceae |
| Genus: | Aspergillus |
| Species: | A. desertorum
|
| Binomial name | |
| Aspergillus desertorum (Samson & Mouchacca) Samson, Visagie & Houbraken (1974) Samson, Visagie & Houbraken (2014)[1]
| |
| Type strain | |
| CBS 653.73, IFO 30840, IMI 343076, NBRC 30840, NRRL 5921[2] | |
| Synonyms | |
|
Emericella desertorum[3] | |
Aspergillus desertorum is a species of fungus in the genus Aspergillus which has been isolated from desert soil.[4][5][3][1] It is from the Nidulantes section.[6] Aspergillus desertorum produces desertorin A, desertorin B, desertorin C, paxiline and emindol DA.[7][8][9][10]
In 2016, the genome of A. desertorum was sequenced as a part of the Aspergillus whole-genome sequencing project - a project dedicated to performing whole-genome sequencing of all members of the genus Aspergillus.[11] The genome assembly size was 29.04 Mbp.[11]
Growth and morphology
A. desertorum has been cultivated on both Czapek yeast extract agar (CYA) plates and Malt Extract Agar Oxoid® (MEAOX) plates. The growth morphology of the colonies can be seen in the pictures below.
-
Aspergillus desertorum growing on CYA plate
Aspergillus desertorum growing on CYA plate -
 Aspergillus desertorum growing on MEAOX plate
Aspergillus desertorum growing on MEAOX plate
References
- ^ a b "Aspergillus desertorum". www.mycobank.org.
- ^ "Emericella desertorum Taxon Passport - StrainInfo". www.straininfo.net. Archived from the original on 2017-04-04. Retrieved 2017-04-03.
- ^ a b "Aspergillus desertorum". www.uniprot.org.
- ^ Samson, R. A.; Mouchacca, J. (1974). "Some interesting species of Emericella and Aspergillus from Egyptian desert soil". Antonie van Leeuwenhoek. 40 (1): 121–131. doi:10.1007/BF00394559. PMID 4545193. S2CID 26536814.
- ^ "Emericella%20desertorum - Global Catalogue of Microorganisms". GCM.WFCC.info.
- ^ Chen, A.J.; Frisvad, J.C.; Sun, B.D.; Varga, S.; Kocsubé, S.; Dijksterhuis, J.; Kim, D.H.; Hong, S.-B.; Houbraken, J.; Samson, R.A. (2016). "Aspergillus section Nidulantes (formerly Emericella): Polyphasic taxonomy, chemistry and biology". Studies in Mycology. 84: 1–118. doi:10.1016/j.simyco.2016.10.001. PMC 5198626. PMID 28050053.
- ^ R.D.H. Murray, Progress in the Chemistry of Organic Natural Products; J.A. Robinson (1991). Tamm, Ch.; W. Herz; G.W. Kirby; W. Steglich (eds.). Fortschritte der Chemie organischer Naturstoffe. Vienna: Springer Vienna. ISBN 978-3-709-19141-5.
- ^ Betina, Vladimír, ed. (1993). Chromatography of mycotoxins techniques and applications. Amsterdam: Elsevier. ISBN 978-0-080-85862-3.
- ^ Wink, Michael, ed. (1999). Functions of plant secondary metabolites and their exploitation in biotechnology (1st ed.). Sheffield: Sheffield Acad. Press. ISBN 978-1-841-27008-1.
- ^ Buckingham, J.; I.W. Southon; et al., eds. (1989). Dictionary of alkaloids (1st ed.). London: Chapman and Hall. ISBN 978-0-412-24910-5.
- ^ a b "Home - Aspergillus desertorum CBS 653.73 v1.0".
Further reading
- Cordell, Geoffrey A., ed. (2003). The alkaloids. Amsterdam: Elservier Academic Press. ISBN 978-0-080-52149-7.
- R.H. Thomson, ed. (1993). The Chemistry of natural products (Second ed.). Dordrecht: Springer Netherlands. ISBN 978-9-401-12144-6.
- Martin, Robert (2011). Aromatic Hydroxyketones: Preparation and Physical Properties (3rd ed.). Dordrecht: Springer Science+Business Media B.V. ISBN 978-1-402-09787-4.
- Marco A., van den Berg; Karunakaran, Maruthachalam (2014). Genetic Transformation Systems in Fungi, Band 2. Springer. ISBN 978-3-319-10503-1.
- Krishnaswamy, N.R. (1999). Chemistry of natural products : a unified approach. Hyderabad, India: Universities Press. ISBN 978-8-173-71093-3.
- Rizzacasa, Mark A.; Sargent, Melvyn V. (1 January 1988). "The synthesis of desertorin C, a bicoumarin from the fungus Emericella desertorum". Journal of the Chemical Society, Perkin Transactions 1 (8): 2425–2428. doi:10.1039/P19880002425. ISSN 1364-5463.
- Samson, R. A.; Mouchacca, J. (1974). "Some interesting species of Emericella and Aspergillus from Egyptian desert soil". Antonie van Leeuwenhoek. 40 (1): 121–131. doi:10.1007/BF00394559. PMID 4545193. S2CID 26536814.